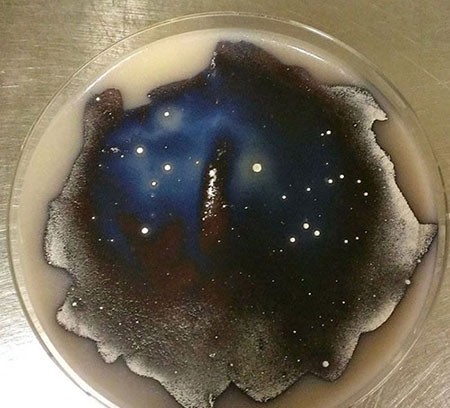
اخبار,اخبار گوناگون, میکروبیولوژیست
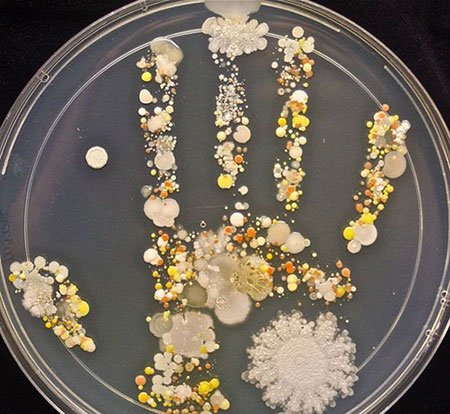
اخبار,اخبار گوناگون, میکروبیولوژیست
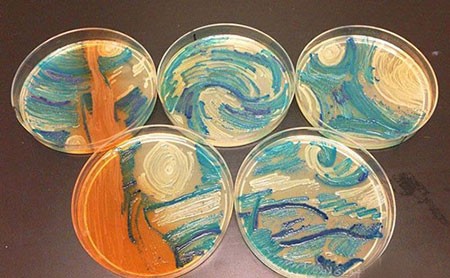
اخبار,اخبار گوناگون, میکروبیولوژیست
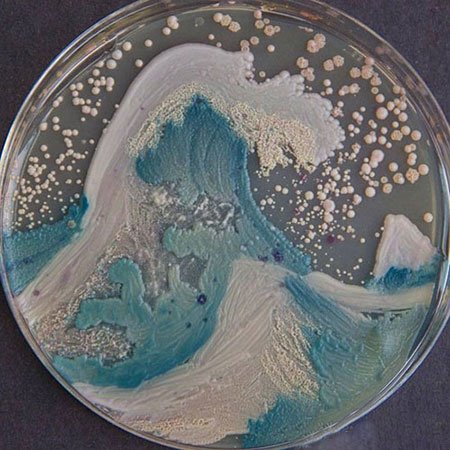
اخبار,اخبار گوناگون, میکروبیولوژیست

قلب خوب یا بد داریم؟ اگر داریم، یک قلب خوب چهویژگیهایی دارد؟ اینها سوالاتی هستند که ممکن است از یک پزشک بپرسید که قطعا ما جوابشان را نمیدانیم اما اگر همین سوالات را درباره قلب خودروها یا همان پیشرانهها بخواهید بدانید، جای درستی آمدهاید.
به گزارش بازار خبر، در این مطلب میخواهیم به فهرست دهگانه سال 2015 بپردازیم. که از سوی یک نشریه معتبر بین المللی که هرساله 10 پیشرانهای کارآمد که در آن سال تولید شدهاند را بهعنوان بهترین پیشرانههای جهان انتخاب میکند معرفی شده است.
مهمترین پایههای امتیازدهی در این تست قدرت و گشتاور خروجی پیشرانه و همچنین متغیر NVH (که معنای صدا، لرزش و تکان را میدهد) است.
1- پیشرانه 127 کیلوواتی بامو آی 30


بامو i3 افتخارات بسیاری باخود بههمراه دارد. یکی از آنها قلبیاست که در زیر کاپوت آن خوابیده. پیشرانه 127 کیلوواتی بامو i3 بیش از 170 اسببخار قدرت دارد و نزدیک به 250 نیوتنمتر توان برای کنده شدن چرخها را در اختیار راننده میگذارد که البته شاید درمقایسه با پیشرانههای بنزینی غولآسا مانند پیشرانه اونتادور حرف آنچنانی برای گفتن نداشته باشد اما نکته جالب در این است که پیشرانه برقی i3 این قدرت و توان را از یک موتور 0.7 لیتری (یا بهعبارت دقیقتر 647 سیسی) بدست میآورد. لازم به ذکر است که نیروگاه بامو i3 بهتنهایی میتواند بیشاز 240 کیلومتر را با یک بار شارژ طی کند.
2- قلب 6.2 لیتری شورولت کوروت با آرایش 8 بطن ویشکل!


از یک پیشرانه اصطلاحا ریزهمیزه 647 سیسی یکباره رسیدیم به پیشرانهای 6.2 لیتری. کوروت اِستینگرِی جدید؛ قبلتر هم تواناییهای خود را ثابت کرده بود و نشان داده بود که با پیشرانه 6.2 لیتری V8 خود میتواند بهراحتی تا بیش از 320 کیلومتربرساعت سرعت بگیرد. این بمب به نسبت قیمت ارزان خود 460 اسببخار را درمدل پایه کوروت دراختیار راننده قرار میدهد. نکته دیگر ماجرا این است که این بلوک تقریبا کوچک که به راحتی در کوروت استینگری جا خوش کرده است، میتواند 630 نیوتنمتر را در دورموتور 4600 به تایرها منتقل کند. این یعنی اینکه اگر راننده حرفهای نباشد با توان و شتاب 3.8 ثانیهای این کوروت حسابی کار دست خودش میدهد!
3- موتور 6.2 لیتری سوپرشارژ داج چلنجر هلکت


داج مدتها بر روی شبیهسازی یک هیولا کار میکرد. این هیولا یا پیشرانه 6.2 لیتری که داج بر روی چلنجر و چارجر هلکت جدید خود قرار داد با همراهی سوپرشارژ میتواند قدرت اعجاب انگیز 707 اسببخار را تولید کند. در بحث کشش و توان برای کندهشدن از زمین، چلنجر هلکت میتواند با سود بردن از گشتاور 880 نیوتنمتری که این پیشرانه به آن میدهد در 10.8 ثانیه مسافت یک چهارم مایل را طی میکند. پیشرانه هلکت از نوع HEMI نسل سوم است که با ورود رسمی به بازار سطح استاندارد بین المللی ساخت پیشرانهها را دگرگون ساخت.
4- سه سیلندر، یک لیتر حجم و هزار سودا!


با فاصله گرفتن از پیشرانه 700 اسببخاری چلنجر به قلب کوچک فورد میرسیم که درمقابل گزینههای پیشین مانند موجودات لیلیپوتی است. چراکه این پیشرانه یک لیتری سه سیلندر که وظیفه پمپاژ کردن قدرت را در فورد فیستا دارد به مدد توربوشارژ خود میتواند قدرتی معادل 123 اسببخار و 169 نیوتنمتر را در اختیار راننده بگذارد.
5- پیل سوختی 100 کیلوواتی هیوندای توسان FCV


گزینه پنجم برترین پیشرانههای 2015 بیشتر از آنکه بطن و دهلیز (یعنی دراینجا سیلندر و پیستون) داشته باشد و پیشرانهای بنزینی قلمداد شود، یک پیل سوختی است که در فرآیندی شیمیایی و مستقیم سوخت را به نیروی الکتریکی تبدیل میکند. مهندسین هیوندای برای این نیروگاه یک کار بینظیر را بهانجام رساندهاند و پیل سوختی که ساختهاند و آن را در زیر کاپوت توسان قرار دادهاند که با تبدیل هیدروژن به الکتریسیته، حدود 135 اسببخار را به چرخها منتقل میکند.
6- پیشرانه 1.5 لیتری توربوشارژ مینیکوپر


مقام ششم فهرست بازهم به پیشرانهای کوچک اختصاص مییابد. مینیکوپر با سود بردن از پیشرانه 3 سیلندر 1.5 لیتری توربوشارژ خود آنهم با قیمت جهانی 20 هزار دلار نهتنها خودرویی نسبتا خوش قیمت به حساب میآید بلکه با 134 اسببخار قدرت و 220 نیوتنمتر گشتاوری که شتاب صفر تا صد را 8 ثانیهای را بهارمغان میآورد، میتواند اندکی لذت سواری اسپرت را نیز بهشما منتقل کند.
7- ورود به عصر پیکاپهای اقتصادی با پیشرانه 3 لیتری داج رم


استفاده از پیشرانههای اقتصادی و مقرون به صرفه در دنیای پیکاپها نیز درحال باب شدن است که فیات-کرایسلر و محصول داج رم 1500 آن، از این قائده مستثنی نیست. ما با پیشرانهای که فورد بر روی F-150 خود قرار داد هم متوجه این موضوع شده بودیم. پیشرانه 3 لیتری توربو دیزل فیات-کرایسلر که نشان اکودیزل را نیز بر روی خود دارد با تقسیم بندی این حجم موتور در بین 6 سیلندر V شکل میتواند 240 اسببخار را در دورموتور 3600 و 560 نیوتن.متر گشتاور در دور موتور 2000 تولید نماید. بیشتر بخشهای این پیشرانه از آلیاژ آهن ساخته شده و باقی بخشها مانند سرسیلندر آن آلومنیومی است.
8- سوبارو: خیالتان تخت با پیشرانههای تخت!


سوبارو همانند پورشه مدتهاست که استفاده از پیشرانههای باکسر را در برنامههای خود نگاهداشته و به استفاده از آنها اصرار میوزد. سوبارو ژاپنی برای محبوبترین سری خودروهای خود (مدل WRX) بهترین پیشرانههایش را درنظر میگیرد و مدل جدید نیز جدا از این جریان نیست مهمترین نکته این پیشرانه این است که 330 نیوتنمتر گشتاوری را که در فارستر و در دورموتور 4800 بهنمایش میگذاشت این بار در WRX در بازه تحسین برانگیز 2000 تا 5200 در اختیار راننده میگذارد.
9- گلف و نیروگاه چهار سیلندر 1.8 لیتری


فولکس واگن گلف جدید و پیشرانه آن دلایل بسیاری برای قرار گرفتن در فهرست 10 پیشرانه برتر دارند. قلب 1.8 لیتری چهارسیلندر فولکسواگن مصداق بارز این مسئله است که این کمپانی همچنان در ساخت خودروهایی با عملکرد فوقالعاده از لحاظ نسبت هزینه به فایده، موفق است. این پیشرانه که در سایت مکزیک فولکس واگن بر روی گلف، بیتل و پاسات مونتاژ میشود 170 اسببخار قدرت را درکنار 270 نیوتن.متر گشتاور تولید میکند. بلوک پیشرانه از چدن ساخته شده و سرسیلندر آن آلومنیومی است.
10- ولو S60 با پیشرانه 2 لیتری چهارسیلندر


برنده نهایی رقابت ده پیشرانه برتر سوار بر ولوو S60 سدان وارد فهرست میشود. این پیشرانه تمام آلومنیومی با حجم دقیق 1969 سیسی و نسبت تراکم 10.8:1 میتواند 240 اسببخار را در دور موتور 5600 تولید کند. گشتاور این پیشرانه که علاوه بر X60 بر روی XC90 نیز نصب میشود 350 نیوتن.متر است.
اخبار گوناگون - بازار خبر